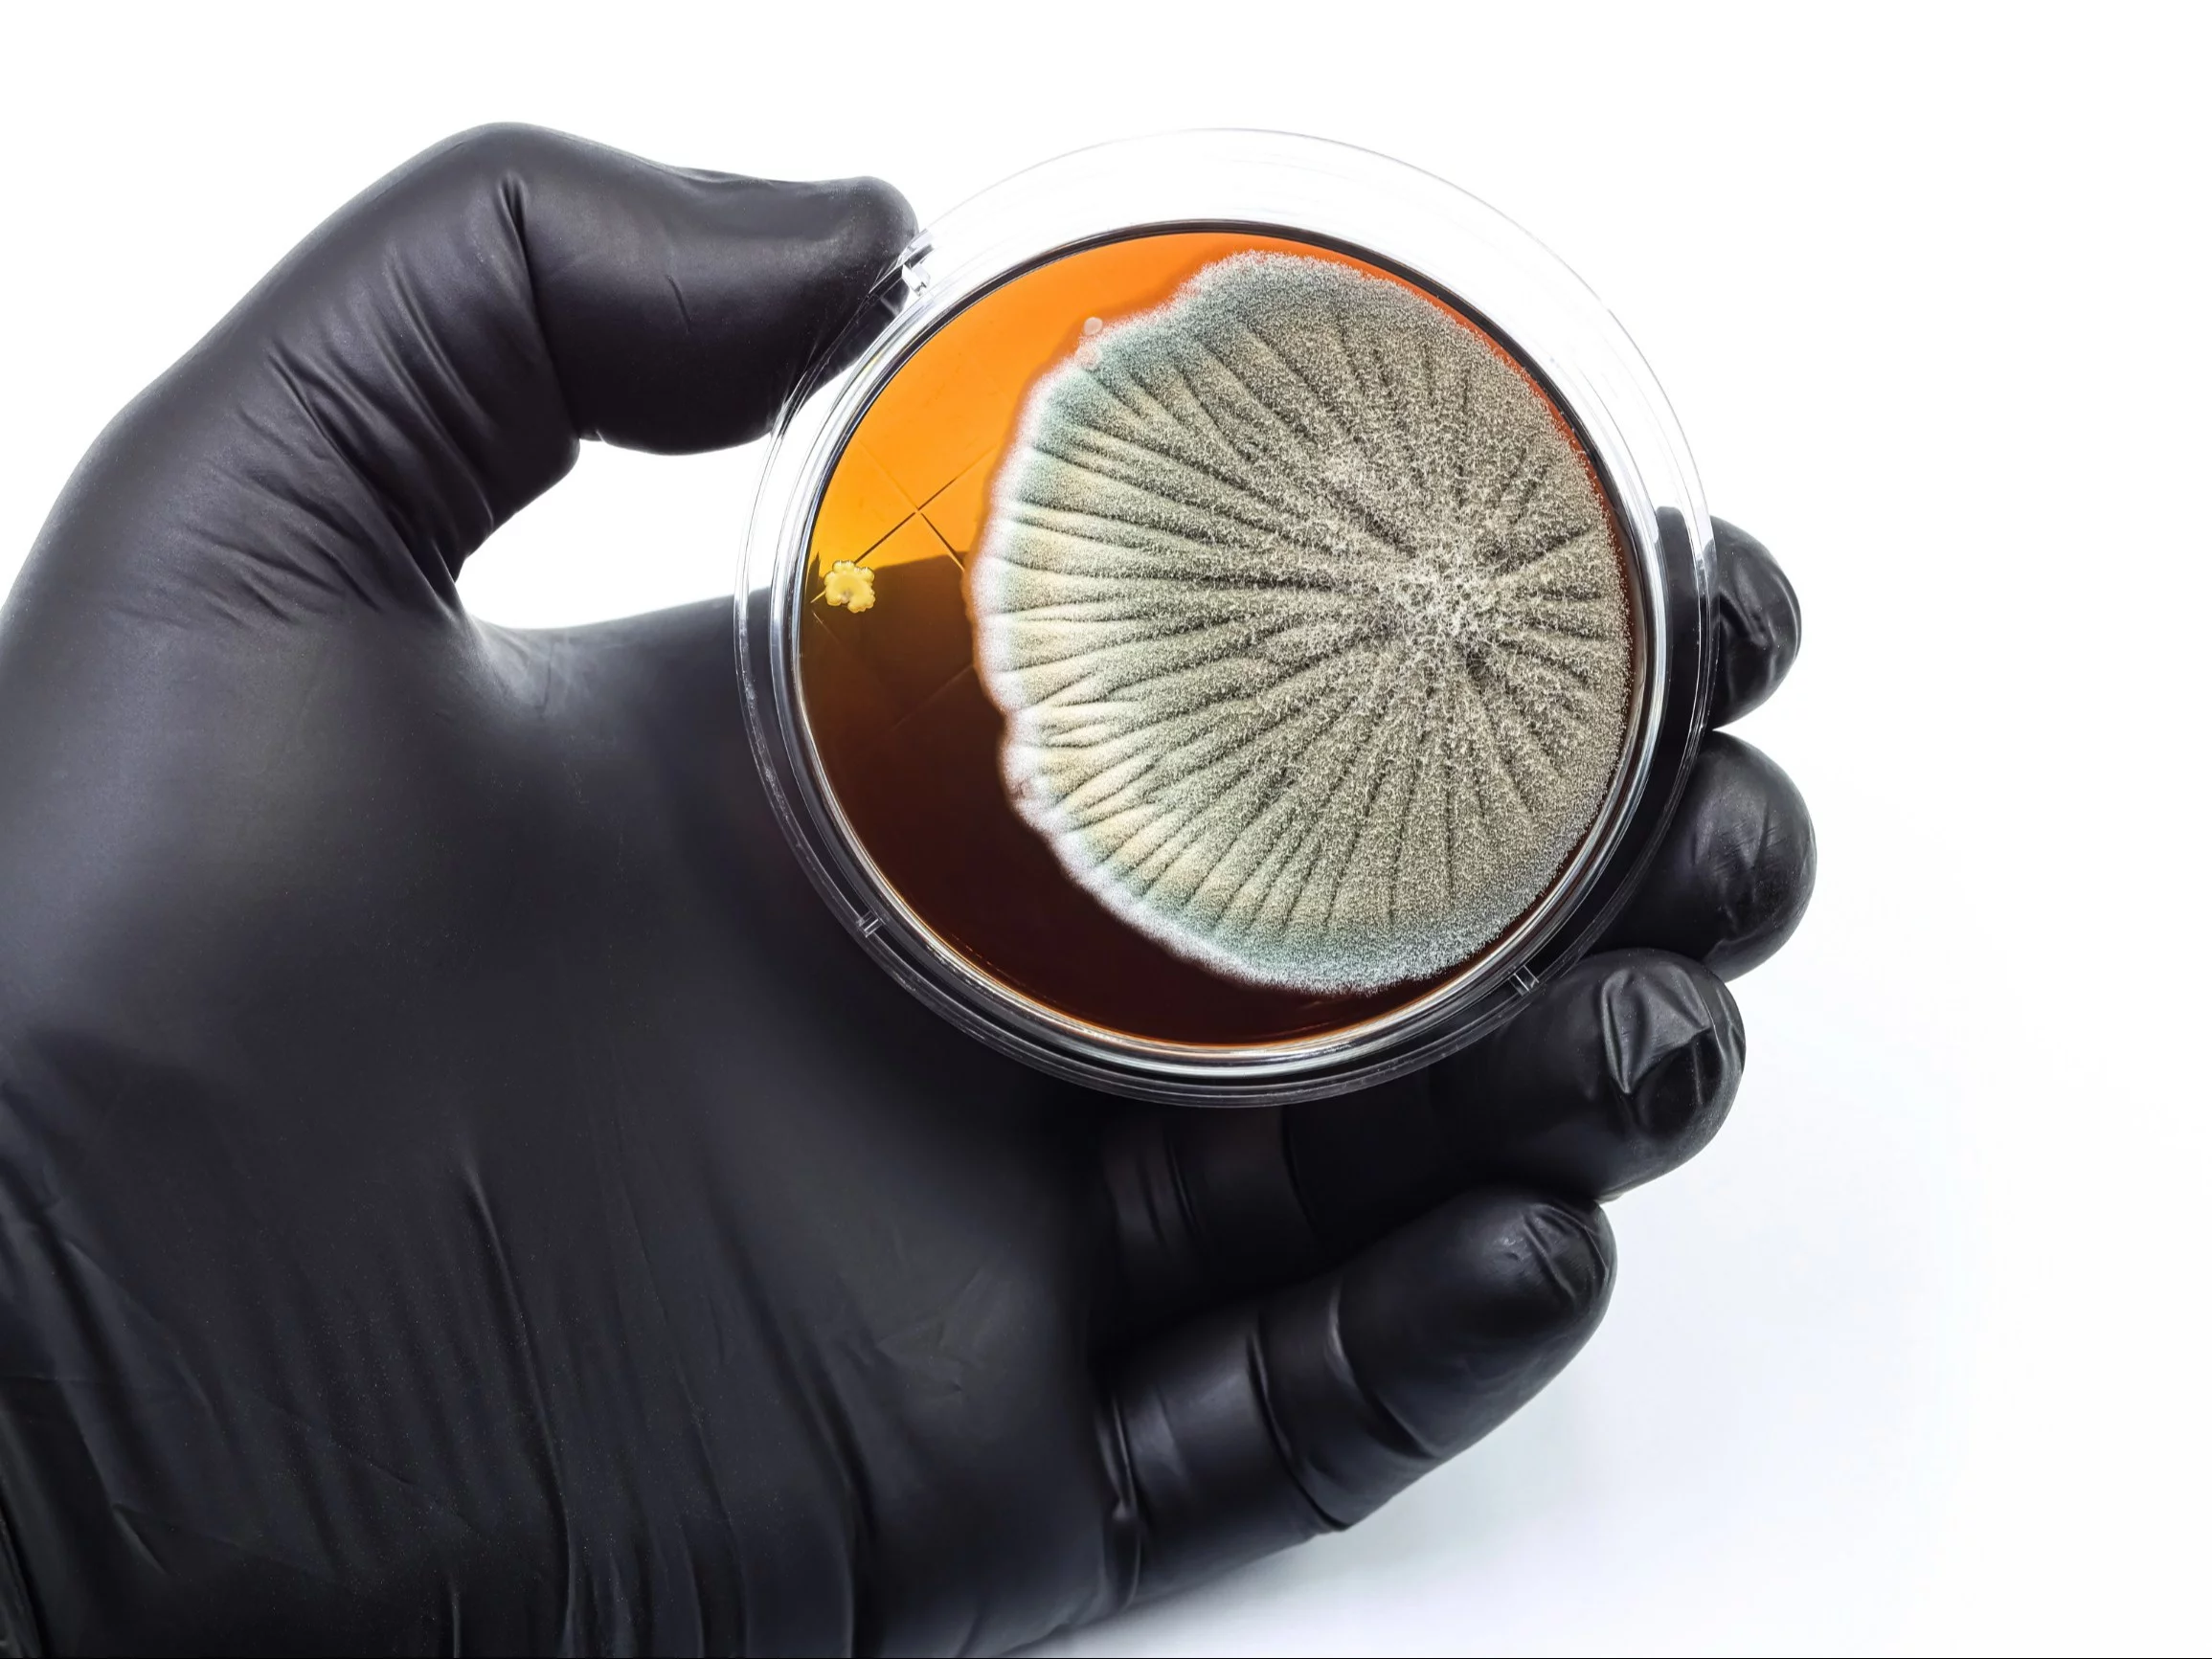
Grzyb

Tak wynika z analizy przeprowadzonej przez naukowców z Uniwersytetu Jagiellońskiego – Collegium Medicum i University of Manchester. Ich zdaniem rzeczywista skala tych chorób jest znacznie większa, niż dotąd sądzono. Wyniki opublikowano w czasopiśmie Scientific Reports (Nature Portfolio).
Zakażenia głównie w szpitalach
Badacze z Uniwersytetu Jagiellońskiego – Collegium Medicum, we współpracy z jednym z najwybitniejszych światowych ekspertów w dziedzinie mykologii medycznej – prof. Davidem W. Denningiem z University of Manchester, twórcą i wieloletnim dyrektorem organizacji Global Action for Fungal Infections (GAFFI) – przeanalizowali polskie dane demograficzne, zdrowotne i literaturowe, aby po raz pierwszy oszacować rzeczywiste obciążenie kraju poważnymi zakażeniami grzybiczymi.
Najgroźniejsze zakażenia grzybicze to kandydemia, czyli obecność komórek Candida we krwi. To jedno z najcięższych zakażeń szpitalnych – rozwija się u pacjentów w ciężkim stanie, po operacjach, w immunosupresji lub na oddziałach intensywnej terapii. W Polsce może dochodzić do kilkuset, a nawet kilku tysięcy przypadków rocznie, a śmiertelność pozostaje bardzo wysoka – zaznacza CM UJ na swojej stronie.
Silnie niedoszacowana jest natomiast aspergiloza płuc – zarówno inwazyjna, przebiegająca gwałtownie i często śmiertelnie, jak i przewlekła, prowadząca do postępującego uszkodzenia płuc. Łącznie obie postacie mogą dotyczyć ponad dziewięciu tysięcy osób rocznie, co stawia aspergilozę wśród najczęstszych ciężkich zakażeń grzybiczych w Polsce.
Rzadkie, ale szczególnie dramatyczne postacie to kryptokokoza, zajmująca najczęściej ośrodkowy układ nerwowy, oraz mukormykoza, wywoływana przez pleśnie oporne na większość leków przeciwgrzybiczych. W Polsce notuje się około 30 przypadków kryptokokozy i 60 mukormykozy rocznie. Obie choroby mają gwałtowny przebieg i wyjątkowo wysoką śmiertelność, szczególnie u osób z ciężkimi zaburzeniami odporności.
Ciężkie grzybice nie są rzadkością
Specjaliści podkreślają, że nie można też zapominać przewlekłych zakażeniach, takich jak nawracająca grzybica sromu i pochwy (rVVC). Choć nie zagraża życiu, dotyczy nawet kilkudziesięciu tysięcy kobiet rocznie i w istotny sposób pogarsza komfort życia, stanowiąc najczęstszy przykład utrwalonej grzybicy o znaczeniu społecznym.
– Ciężkie zakażenia grzybicze w Polsce nie są rzadkością. Mówimy o kilku tysiącach przypadków rocznie – porównywalnie z częstością wielu chorób cywilizacyjnych. Kluczowe znaczenie ma szybsza diagnostyka, właściwe raportowanie i dostęp do skutecznego leczenia – podkreśla dr n. med. Paweł Krzyściak z Katedry Mikrobiologii, Wydział Lekarski UJ CM, autor korespondencyjny pracy.
Szacunki pokazują, że łącznie poważne grzybice mogą dotyczyć ponad 100 tys. pacjentów rocznie. To liczba porównywalna z hospitalizacjami z powodu zawałów serca czy ciężkich przypadków grypy. Różnica polega na tym, że o grypie mówi się co roku – o grzybicach prawie wcale.
Czytaj też:
Są dalekosiężne skutki szczepień. 7 mało znanych faktówCzytaj też:
Od dziś darmowe szczepienia dorosłych w aptekach. Na liście kilkanaście pozycji